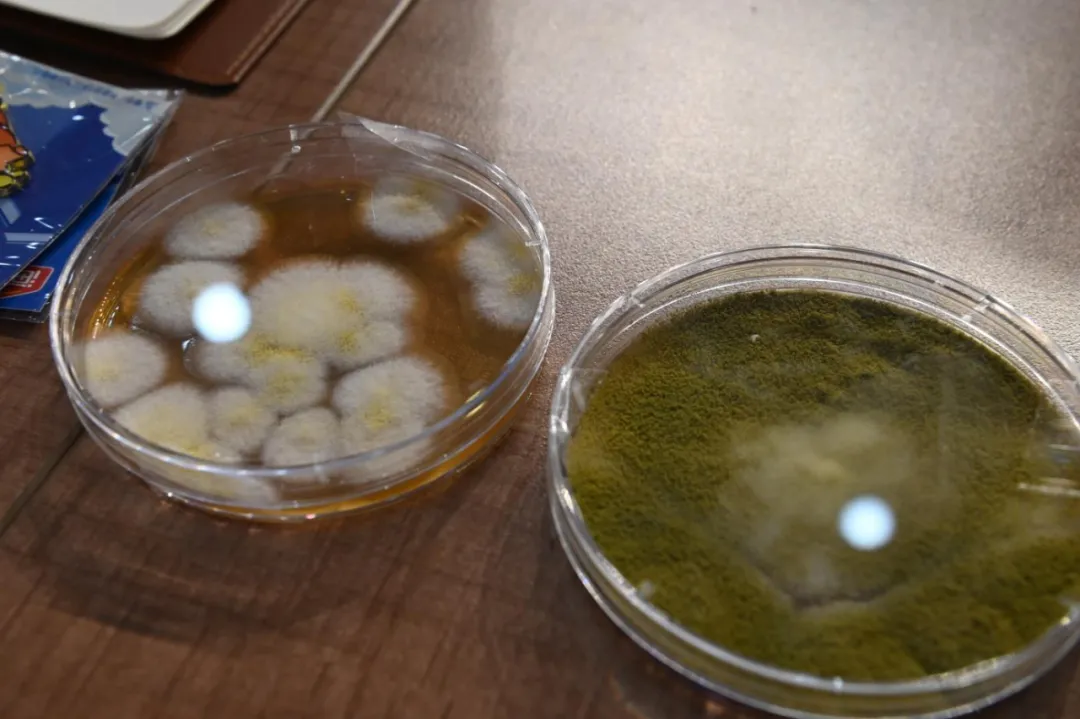

2024年9月康泽基金会与海天科普志愿服务队携手开展了首次“科普大求真”系列活动,不知不觉中已经一周年了!在这一年中科普大求真的志愿者们走进了学校、社区、工厂、商场和医院,面向不同群体分享了生动有趣、科学有料的营养健康科普知识,受到了广泛好评。迄今已开展活动28场,并使6600多人受益。
2025年9月12日,在与佛山市南海区人民医院、弘爱社会工作服务中心的合作下,我们将营养科普带进了医院产科,由医院产科叶主任开展《孕期全程营养守护》专题讲座,并通过志愿者组织摊位科普活动,帮助准妈妈们建立起全面、科学的膳食观念。



多数孕妇都表示有贫血现象,以至于需要服用补铁剂,现场也向大家科普了营养改善缺铁性贫血的关系。


2025年9月13-14日期间,在佛山市消费者委员会、佛山保利水城商场、海天公司品牌部、客服部的科普志愿者的支持下,我们面向市民以及小朋友开展了科普宣传活动,重点讲解特殊饮食需要,以及调味品保管相关知识。
经过我们科普志愿者的前期走访,发现不少村居长者家里正在使用的调味品,已经出现过期、轻微变质的情况,这在困境长者、独居长者家庭中更为常见,我们也呼吁从细节处关注长者健康。



2025年9月19日海天科普志愿者、高明公司质量总监刘老师来到了佛山市德恒精英学校,用自己的专业知识和日常工作经验,为全校200多名师生讲解微生物与发酵工业的奥秘,极大地激发了学生对科研的兴趣。






2025年9月28日海天科普志愿者、研究院童星院长、工艺所徐睿泉工程师来到了禅城区澜石小学,向现场200余名学生,以及通过直播观看的500多名学生,通过《一粒黄豆的鲜美旅程》讲解了黄豆与发酵工艺的知识。

澜石小学此前已经组织学生在学校里面的园地种植黄豆,通过这节科普讲座活动,让学生们更加了解黄豆的成分以及转化的路径。

2025年9月正好是我们开展科普活动的一周年,特别感谢这一年中支持活动开展的科普讲师、助教志愿者,各学校和负责协调组织的老师们,以及科协、消协等有关单位。接下来我们除了继续开展科普活动,还将更加注重科普资源整合,将科普知识覆盖到更广阔的地区。